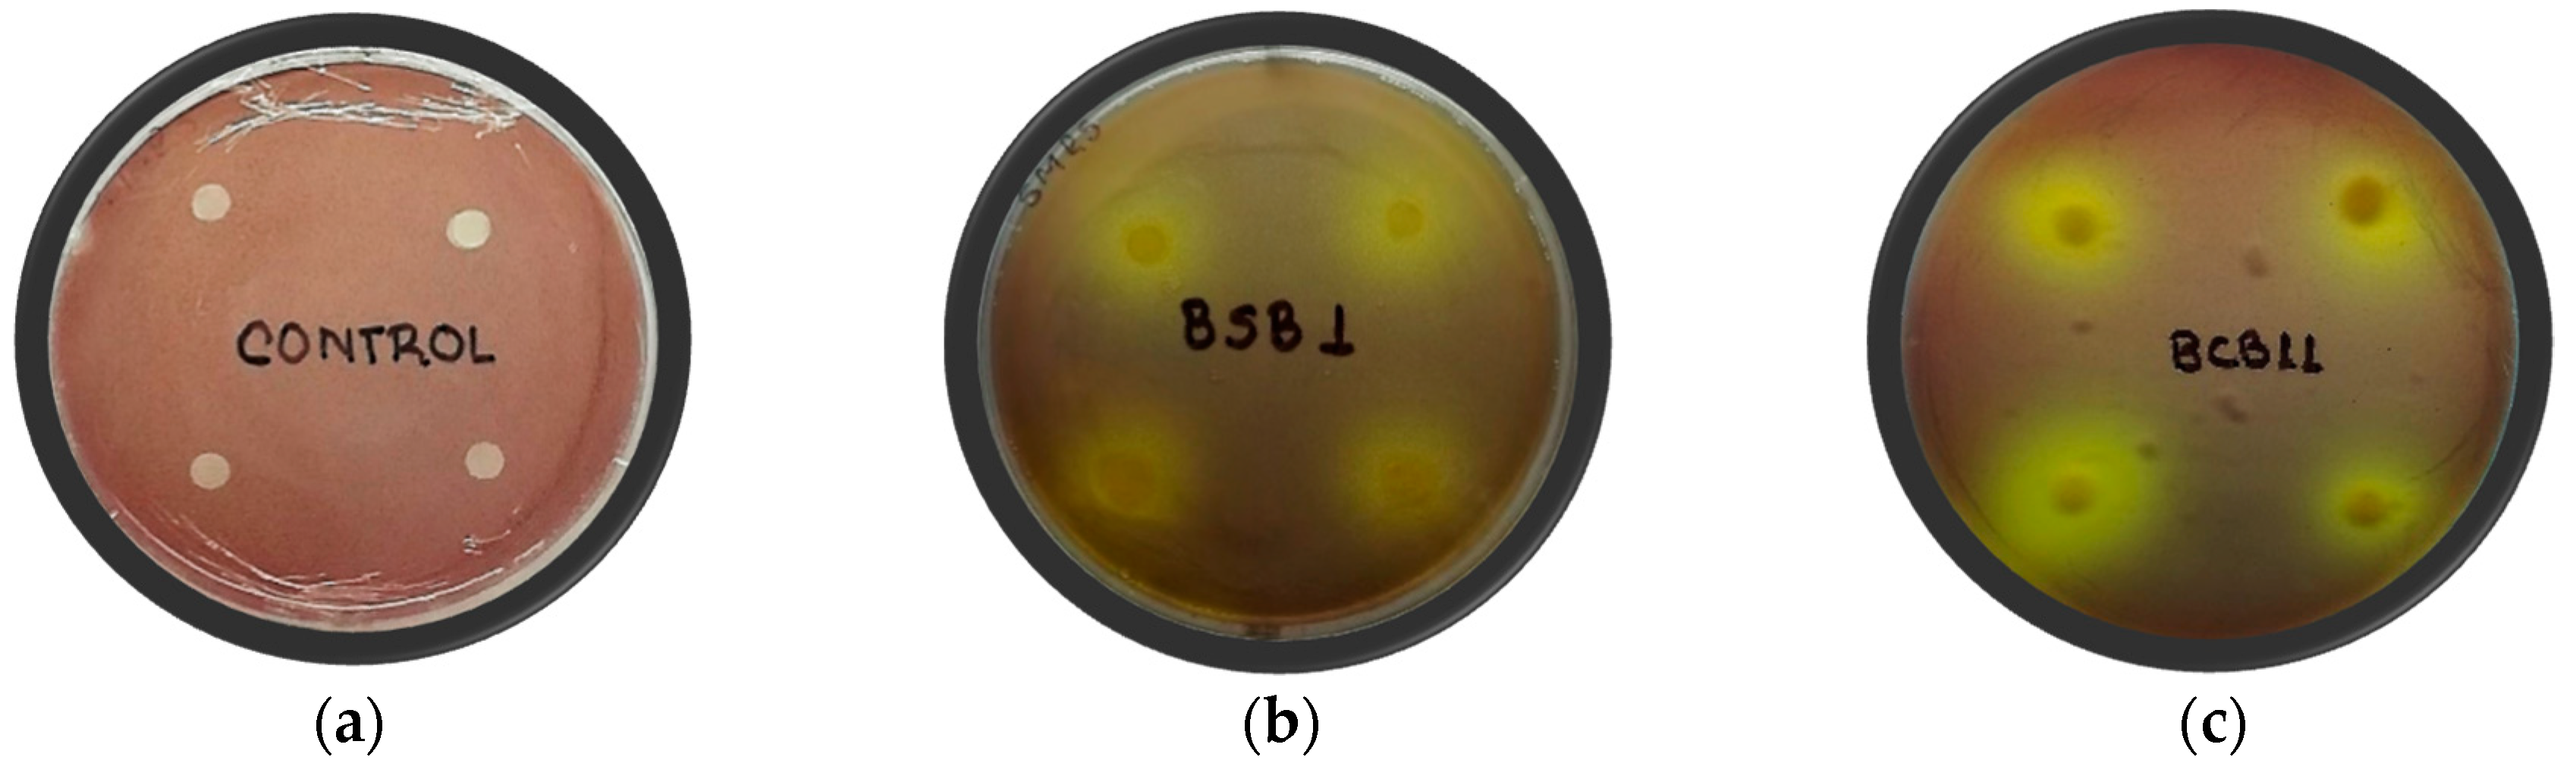

Botanical Garden Of Georgia Inorganic Young Investigator
Botanical Garden Of Georgia Inorganic Young Investigator, Indeed recently has been hunted by consumers around us, perhaps one of you personally. People now are accustomed to using the internet in gadgets to view video and image information for inspiration, and according to the name of this article I will discuss about
If the posting of this site is beneficial to our suport by spreading article posts of this site to social media marketing accounts which you have such as for example Facebook, Instagram and others or can also bookmark this blog page.
Https Www Chicagobotanic Org Sites Default Files Pdf Cbg Keep Growing 2019 Summer Pdf Rose Garden Kew Organic Foods Healthy
Mcdevitt phd has been awarded the 2010 young investigator award from the society of biomaterials sfb.
Rose garden kew organic foods healthy. Mcdevitt will receive the award at the 2010 annual meeting to be held in seattle. Georgia tech christopher moore. The friersons are uga alumni.
I went to the university of british columbia to visit the campus but ended up spending most of my time in the various gardens including the rose garden shown here the nitobe japanese garden and the ubc botanical garden and plant research centre. In 2015 they received the jere w. The one thousand plant transcriptomes initiative 1kp is a global collaboration to examine the diversification of plant species genes and genomes across the more than 1 billion year history of green plants dating.
Chihuly in the garden weaves together art. An evening at the atlanta botanical gardens tuesday may 25 2004 atlanta botanical gardens 630 1000 pm sponsored by enjoy an elegant evening at the atlanta botanical gardens featuring the stunning glass artwork of dale chihuly within the gardens lush setting. In 2016 they were named state botanical garden of georgia giving tree tribute distinguished honorees.
Ann earned a bachelors degree in sociology and joe earned a bachelors degree in political. Lehmann that instead of boxwoods she and her fellow volunteers should plant native species which would attract pollinators insects and create a waypoint for animals and humans between. Case investigator georgia department of public health.
The young investigator award recognizes an individual each year who has demonstrated outstanding achievements and leadership in the field of biomaterials research. State botanical garden. Daniel atha a botanist at the new york botanical garden who lives near the park joined the group after meeting them at a volunteer drive.
The state botanical garden of georgia the garden is a 313 acre preserve set aside by uga in 1968 for the study and enjoyment of plants and nature. Assistant professor todd c. Morehead award for distinguished service and support of the uga honors program.
Located three miles south of campus it is a living laboratory serving educational research recreational and public service roles for the university and the citizens of georgia. First author kazumi ozaki l and principal investigator chris reinhard r in reinhards lab at georgia techs school of earth and atmospheric sciences. I work with a team that cares for bettering the education of children from as young as the age of 3 until 18.
Https Www Wacker Com Cms Media En Asset About Wacker Wacker At A Glance Annual Report Annual Report 19 Pdf Rose Garden Kew Organic Foods Healthy